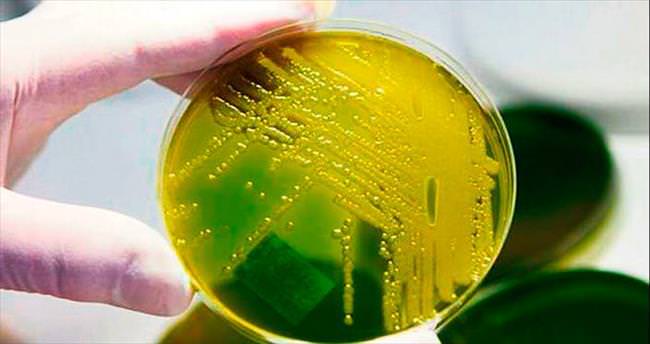

Almanya'nın kuzeyindeki Schleswig-Holstein eyaletinde Kiel Üniversite Hastanesi Kliniği, bir ayı aşkın bir süredir yayılan birbakteriyle mücadele ediyor. Kamuoyu ise durumdan tesadüf eseri haberdar oldu. Türkiye tatilinden dönen 74 yaşındaki bir erkek Alman hasta, 11 Aralık'ta Kiel Üniversite Hastanesi Kliniği'nin acil servisine başvurdu. 21 Aralık-20 Ocak tarihleri arasında kendisiyle birlikte aynı bakteriyi taşıdığı tespit edilen hastanedeki 10 hasta daha yaşamını yitirdi. Hastane yetkilileri vakalardan 9'unda bakterinin ana ölüm nedeni olmadığını belirtiyor.
GAZETECİLER ORTAYA ÇIKARDI
Cumartesi akşamına kadar yaşları 27 ile 88 arasında değişen 27 hastada neredeyse tüm antibiyotik türlerine karşı bağışıklığı olan Acinetobacter baumannii tespit edildi. Kamuoyu bu durumdan ancak yeni haberdar oldu. Kliniğin 23 Ocak tarihli basın bültenindeki "12 hastaya MRGN bakterisi bulaştığı, yoğun bakım servisine tedbiren şimdilik yeni hasta alınmayacağı, büyük ameliyatların ertelenebileceği" açıklaması gazetecilerin dikkatini çekti. Basın bildirisinde ölen hastalara da değinilmiyordu. Gazetecilerin soruları üzerine sorunun boyutu ortaya çıktı. Cuma akşamı bir basın toplantısı düzenleyen Schleswig-Holstein Üniversite Kliniği Başhekimi Jens Scholz, ölü sayısını önce 3, hemen ardından 5 olarak açıkladı. Eyalet Sağlık Bakanı ile yapılan kriz toplantısının ardından cumartesi akşamı ikinci bir basın toplantısı düzenlendi. Bu kez vücudunda bakteri tespit edilen 11 hastanın 21 Aralık-20 Ocak arasında öldüğü bilgisi verildi. Klinik iki günde bir konuyla ilgili kamuoyunu bilgilendireceğini açıkladı. Scholz, hastanedeki 50 kişide yapılan tarama sonrası 14 kişinin de izolasyonda kalmaya devam ettiği, hastanede yoğun bakım dışındaki bölümlerde bulunan hastalar için bir tehlike bulunmadığı bilgisini verdi.
FRANKFURT'TAN TAKVİYE...
Şu an başsavcılık konuyla ilgili soruşturma yürütüyor. Schleswig-Holstein Üniversite Hastanesi Kliniği, Frankfurt Üniversitesi'ndeki bilim insanlarından yardım istedi. İlgili bakteri konusunda uzman bilim insanlarının Kiel'e hareket ettiği açıklandı. Sağlıklı insanlar için tehlikesiz olan bu bakteri, hastalar ve bağışıklık sistemi zayıf olan kişilerde ise tehlikeli sonuçlara yol açabiliyor.
Deutsche Welle Türkçe
Hastanede gizemli bakteri 11 can aldı
Türkiye tatilinden dönen bir Alman hastanın taşıdığı bakteri, Kiel Hastanesi'nde onlarca hastaya yayıldı. Art arda ölen 11 hastada bakteri tespit edildi
Bu haber toplam 2925 defa okunmuştur
UYARI: Küfür, hakaret, rencide edici cümleler veya imalar, inançlara saldırı içeren, imla kuralları ile yazılmamış,
Türkçe karakter kullanılmayan ve büyük harflerle yazılmış yorumlar onaylanmamaktadır.
Türkçe karakter kullanılmayan ve büyük harflerle yazılmış yorumlar onaylanmamaktadır.
Bu habere henüz yorum eklenmemiştir.
SON EKLENEN GALERİLER
Diğer Haberler
 Japonya’da Satılan Gıda Takviyesi 26 Kişiyi Hastanelik Etti: Piyasadan ToplatılıyorJaponya'da kırmızı pirinç mayasından üretilen ve kötü huylu kolesterolü düşürdüğü iddia edilen gıda takviyeleri kullanan 26 kişiyi hastanelik etti.
Japonya’da Satılan Gıda Takviyesi 26 Kişiyi Hastanelik Etti: Piyasadan ToplatılıyorJaponya'da kırmızı pirinç mayasından üretilen ve kötü huylu kolesterolü düşürdüğü iddia edilen gıda takviyeleri kullanan 26 kişiyi hastanelik etti. Türkiye’nin Diyabet Tedavisindeki Tecrübesi Cezayir’e AktarılıyorTürk İşbirliği ve Koordinasyon Ajansı Başkanlığı (TİKA) tarafından geliştirilen Halk Sağlığı Eğitim Programı (HASEP) çerçevesinde Sağlık ve...
Türkiye’nin Diyabet Tedavisindeki Tecrübesi Cezayir’e AktarılıyorTürk İşbirliği ve Koordinasyon Ajansı Başkanlığı (TİKA) tarafından geliştirilen Halk Sağlığı Eğitim Programı (HASEP) çerçevesinde Sağlık ve... Özbekistan’ın İlk Beyin Pili Ameliyatına Türk Doktorlar İmza AttıÖzbekistan'ın tarihi şehri Semarkant'ta bulunan Semerkant Tıp Fakültesi Beyin Cerrahisi Kliniği'nde, Türkiye'den giden doktorların öncülüğünde ülke...
Özbekistan’ın İlk Beyin Pili Ameliyatına Türk Doktorlar İmza AttıÖzbekistan'ın tarihi şehri Semarkant'ta bulunan Semerkant Tıp Fakültesi Beyin Cerrahisi Kliniği'nde, Türkiye'den giden doktorların öncülüğünde ülke... Bm: “Gazze Şeridi’ndeki 378 Bin Kişi Felaket Düzeyinde Açlıkla Karşı Karşıya”Birleşmiş Milletler İnsani İşler Koordinasyon Ofisi (OCHA), Gazze Şeridi'ndeki 2,3 milyon kişiden 378 binin felaket düzeyinde açlıkla karşı karşıya...
Bm: “Gazze Şeridi’ndeki 378 Bin Kişi Felaket Düzeyinde Açlıkla Karşı Karşıya”Birleşmiş Milletler İnsani İşler Koordinasyon Ofisi (OCHA), Gazze Şeridi'ndeki 2,3 milyon kişiden 378 binin felaket düzeyinde açlıkla karşı karşıya...- 13:25 - ’Göğüs Büyüklüğü Bazı Sağlık Problemlerine Yol Açabilir’
- 13:25 - ’Plastik Ajanlar’ Sağlığı Tehdit Ediyor
- 13:00 - Sahte Güneş Gözlüğünde Görme Kaybı Tehlikesi
- 12:10 - Kkka Hastalığı Hakkında Uyarılarda Bulunan Halk Sağlığı Uzmanı Doktor Nilay İçkilli, “Kulak Arkası, Koltuk Altı, Diz Arkası, Kasık Bölgeleri Sıklıkla Kontrol Edilmeli”
- 11:40 - Gebze’nin Yeni Merkezi Hasta Kabulüne Başladı
- 11:20 - Prof. Dr. Tevfik Özlü: “Astım Ve Koah Hastaları Çöl Tozuna Dikkat Etmeli”
- 09:30 - Uzm. Dr. Kocabaş: “Keneler Patlatılmamalı”
- 09:17 - Karın Ağrısıyla Geldiği Hastanede, 8 Saatlik Ameliyatla Hayata Tutundu
- 09:05 - ’Yılın Doktoru’ Mustafa Doğan Niğde’de Başhekim Oldu
- 09:05 - Gümüşhane’de Son 10 Günde Kene Vakalarında Artış Yaşanıyor
- 09:00 - Bölgenin İlk Kapalı Yöntemle Tüp Açma Operasyonu Tatvan’da Gerçekleştirildi
- 09:00 - Hava Değişimleri Nedeniyle Grip Vakaları Arttı, Servisler Doldu
- 01:10 - Kalp Hastalığı Olan Bebek, Ambulans Helikopterle Ankara’ya Sevk Edildi
- 00:30 - Egeli Bilim Adamlarının Projesine Tübitak’tan Destek
- 10:25 - Titreme Hastalığında ‘Akıllı Sesötesi Tedavisi’ Türkiye’de
- 10:25 - Uzmanı Açıkladı: Doğru Kitapları Okumak Depresyon Ve Anksiyeteyi İyileştiriyor
- 10:15 - Panik Atağın En Önemli Belirtisi ’Felaket Düşüncesi’
- 10:00 - Hava Kirliliği Astıma Neden Oluyor
- 09:20 - Hem Satıyor, Hem De Faydalarını Anlatıyor
- 07:37 - Ambulans Uçak Minik Alya İçin Havalandı
- 02:30 - Sağlık Uygulama Tebliğinde Değişiklik Yapılmasına Dair Tebliğ-21.04.2024
- 01:39 - Sağlık Hizmetleri Fiyatlandırma Komisyonu Kararı-21.04.2024
- 14:04 - İki Yılda 120 Ünite Kan Aldı, Donör Almanya’dan Bulundu
- 14:00 - Yutma Güçlüğü Kanser Habercisi Olabilir
- 13:58 - Iğdır Devlet Hastanesinde Kızamık Alarmı
- 13:55 - Ünlü Oyuncu Alp Kırşan, İeü Medical Point’te Babalık Serüvenini Anlattı
- 13:53 - Hastanelerdeki Yoğunluk Mevsim Normallerinde
- 13:50 - Bayramda Tatlıyı Fazla Kaçırmayın
- 13:48 - Dsö, 2040 Yılına Kadar Yaklaşık 29 Milyon Yeni Kanser Vakası Teşhis Edileceği, Bunun 15 Milyonun İse Kanser Nedeniyle Öleceğini Öngörüyor
- 13:46 - Türkiye’de Uykuda Solunum Bozukluğu Erkeklerde Yüzde 4, Kadınlarda Yüzde 2
- 13:44 - Niğde Ömer Halisdemir Üniversitesi Ağız Ve Diş Sağlığı Merkezi Kalıcı Ruhsatını Aldı
- 13:42 - Çeküs Poliklinikleri Vatandaşları Bekliyor
- 13:39 - Ambulans Helikopter Yeni Doğan Bebek İçin Zamanla Yarıştı
- 13:37 - Tevfik Özlü: "Risklerinizi Bilin, Sağlığınızı Yönetmeyi Öğrenin, Tıbbi Bakım Ve Önerileri Göz Ardı Etmeyin"
- 13:35 - Aydın’da 9 Bin Sağlık Personeli Görev Yapıyor
- 13:32 - Ramazan Ayı Sonrası Yeterli Ve Dengeli Beslenme Önemli
- 13:30 - Anka’da Bayramlaşma Töreni
- 13:28 - Uzman Doktor Uyardı: ‘Kalp Sağlığımıza Dikkat’
- 13:25 - Beslenme Ve Diyet Uzmanı Gülcan Yıldız: “Ramazan Sonrası Beslenmeye Dikkat”
- 13:22 - Uzmanlar Uyarıyor, Bayramda Aşırı Tatlı Gıda Alerjisine Sebep Olabilir
EDİTÖRÜN SEÇTİKLERİ
 Pandemi Hastaneleri konulu duyuru
Pandemi Hastaneleri konulu duyuru Elektif İşlemlerin Ertelenmesi ve Diğer Alınacak Tedbirler konulu duyuru
Elektif İşlemlerin Ertelenmesi ve Diğer Alınacak Tedbirler konulu duyuru 3 Mart 2020 Değişiklik Tebliğleri İşlenmiş Güncel 2013 SUT (SGK)
3 Mart 2020 Değişiklik Tebliğleri İşlenmiş Güncel 2013 SUT (SGK) Sağlık Uygulama Tebliği EK-2/C değişen maddeler ve fiyat ve artış oranları-03.03.2020
Sağlık Uygulama Tebliği EK-2/C değişen maddeler ve fiyat ve artış oranları-03.03.2020 Sağlık Uygulama Tebliği EK-2/B değişen maddeler ve fiyat ve artış oranları-03.03.2020
Sağlık Uygulama Tebliği EK-2/B değişen maddeler ve fiyat ve artış oranları-03.03.2020 Sağlık personeli dinlenme odalarında düzenleme yapılması hakkında duyuru
Sağlık personeli dinlenme odalarında düzenleme yapılması hakkında duyuru
 14 soruda Koronavirüs hakkında kendinizi test edin...
14 soruda Koronavirüs hakkında kendinizi test edin... Asgari Ücret net 2 bin 800 TL DİSK duyurdu AGİ de bakın ne kadar olacak
Asgari Ücret net 2 bin 800 TL DİSK duyurdu AGİ de bakın ne kadar olacak Gilaburu meyvesi kanserden koruyor
Gilaburu meyvesi kanserden koruyor Endonezya’daki deprem: Ölü sayısı bin 203'e yükseldi
Endonezya’daki deprem: Ölü sayısı bin 203'e yükseldi
12345678
 ’Plastik Ajanlar’ Sağlığı Tehdit Ediyor
’Plastik Ajanlar’ Sağlığı Tehdit Ediyor ’Göğüs Büyüklüğü Bazı Sağlık Problemlerine Yol Açabilir’
’Göğüs Büyüklüğü Bazı Sağlık Problemlerine Yol Açabilir’ Sahte Güneş Gözlüğünde Görme Kaybı Tehlikesi
Sahte Güneş Gözlüğünde Görme Kaybı Tehlikesi Kkka Hastalığı Hakkında Uyarılarda Bulunan Halk Sağlığı Uzmanı Doktor Nilay İçkilli, “Kulak Arkası, Koltuk Altı, Diz Arkası, Kasık Bölgeleri Sıklıkla Kontrol Edilmeli”
Kkka Hastalığı Hakkında Uyarılarda Bulunan Halk Sağlığı Uzmanı Doktor Nilay İçkilli, “Kulak Arkası, Koltuk Altı, Diz Arkası, Kasık Bölgeleri Sıklıkla Kontrol Edilmeli”
Tüm Hakları Saklıdır © 2006 Sağlık Aktüel | İzinsiz ve kaynak gösterilmeden yayınlanamaz.
Tel : (0216) 606 17 18 - (0224) 334 1 335 | Faks : (0216) 606 17 19 | Haber Yazılımı: CM Bilişim
Tel : (0216) 606 17 18 - (0224) 334 1 335 | Faks : (0216) 606 17 19 | Haber Yazılımı: CM Bilişim







































